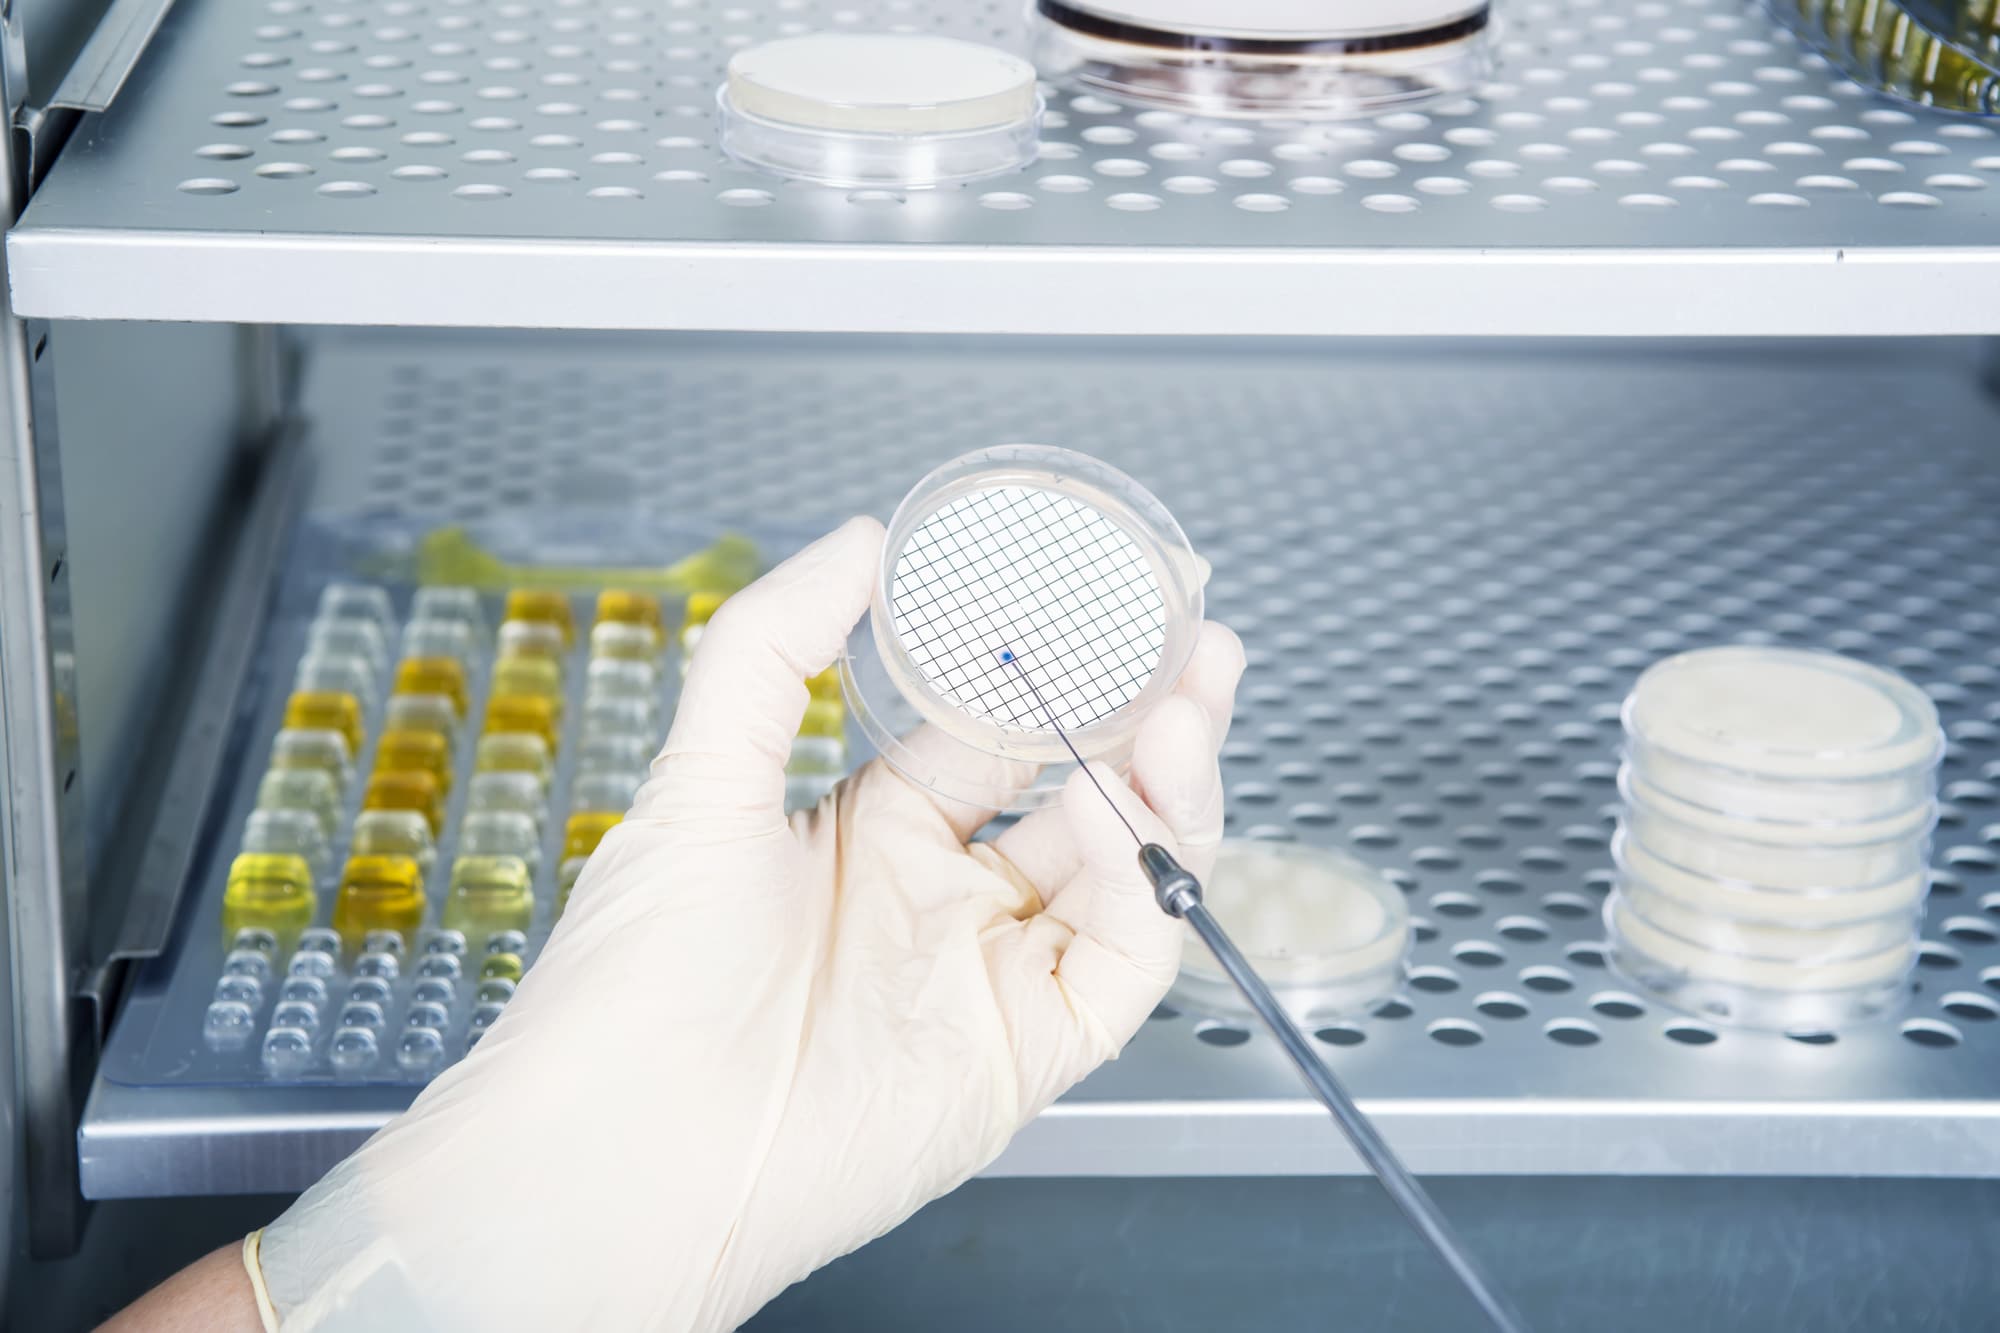

About Rodwell
+44 (0)1268 286646
Chester Hall Lane,
Pipps Hill Industrial Estate,
Basildon, Essex,
SS14 3DQ
Laboratory Sterilisation
You’d imagine a laboratory to be impeccably clean as the thought of germs inside such an environment wouldn’t bear thinking about. With so much apparatus needed on a daily basis it might make you wonder how everything can be kept so sterile? To help with the Laboratory Sterilisation there are devices such autoclaves at work.
The Autoclave can help to sterilise all types of equipment and make sure it’s free from germs. Basic versions of the autoclave have been used for years and stovetop equipment is still used today. Yet the more modern ranges of Laboratory Sterilisation equipment are helping to take the sterilisation process into new realms. Heavy duty versions can meet the demands that busy labs throw at them and they come packed with a host of fine features.
They are built to space saving designs yet are comprehensive enough to cope with rigorous sterilising duties. With automatic drain and re-fill properties the units are extremely user-friendly. They have scale prevention systems and waste discard features, which makes it easier for the operator of the machine. When it comes to Laboratory Sterilisation the autoclave is an out and out winner because it can perform tirelessly every day of the week and make sure that all kinds of equipment is free from germs.
